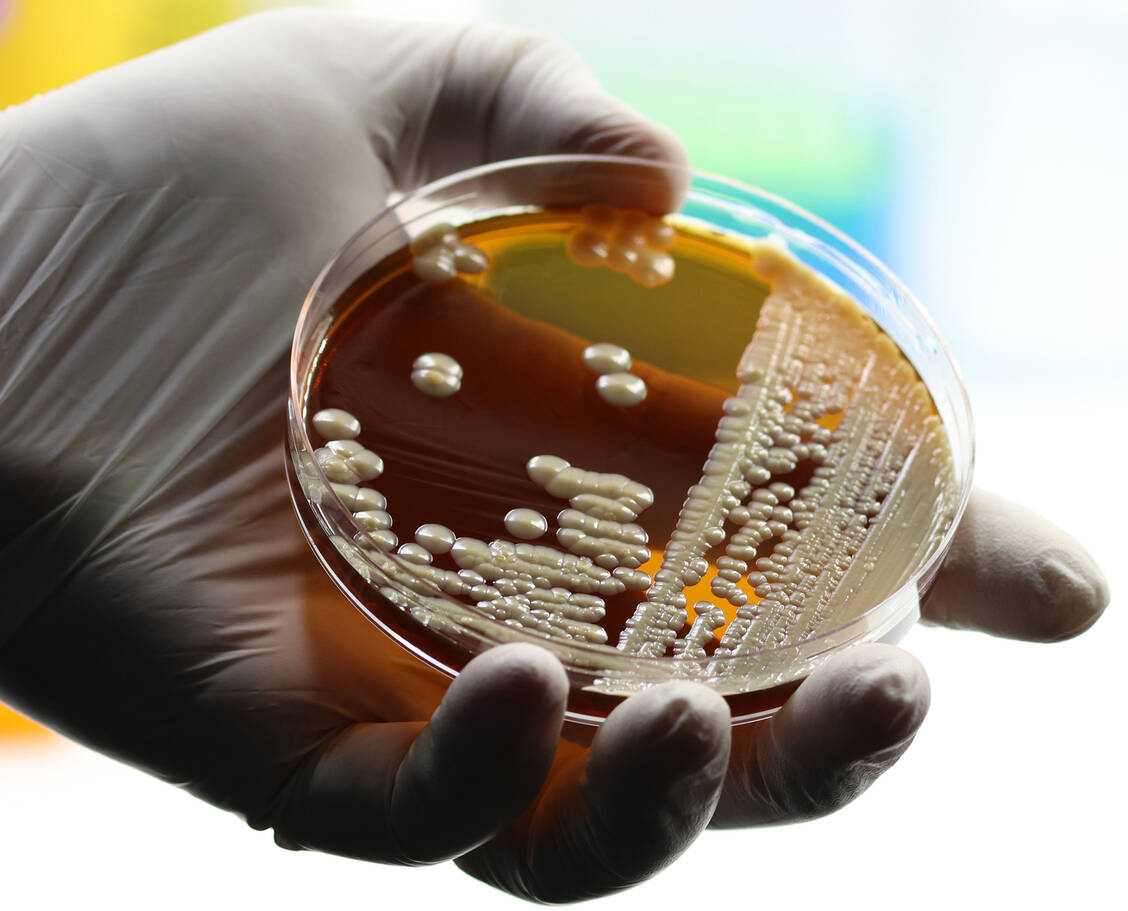

Die geschätzte Zahl der Sterbefälle bezieht sich auf die Jahre 2016 bis 2020, sie zeigt eine Zunahme verglichen mit früheren Schätzungen. »Wir sehen besorgniserregende Anstiege bei der Zahl der Todesfälle, die auf Infektionen mit antibiotikaresistenten Bakterien zurückzuführen sind«, erklärte ECDC-Direktorin Dr. Andrea Ammon im Vorfeld des European Antibiotic Awareness Day am Freitag. Es müsse mehr dafür getan werden, dass Antibiotika nicht unnötig zum Einsatz kommen. Auch Infektionsvorbeugung und Kontrollpraktiken müssten verbessert werden. Antibiotikaresistenzen drohten zunehmend Sorgen zu bereiten, wenn Regierungen nicht engagierter auf die Bedrohung reagierten, hieß es in dem Bericht der Gesundheitsexperten.